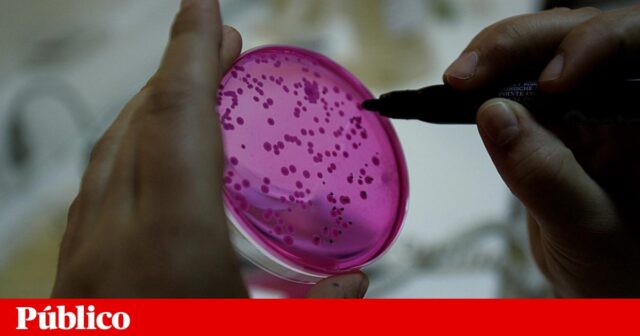
91d0038e4834c25ffe6a40e034362d7c

Cientistas e decisores políticos andam preocupados. As pessoas não percebem a ciência. Não se interessam por ciência. Acreditam em coisas que a ciência afirma serem falsas. Não confiam nos cientistas. Não confiam nos políticos que se baseiam no que os cientistas dizem. Não seguem uma dieta mediterrânica. Continuam a fumar. Ultrapassam os limites de velocidade. Sentam-se debaixo de arribas escalavradas pela erosão. Não sabem distinguir um átomo de um eletrão.
Mais populares
Covid-19: Portugal terá “níveis muito baixos” de novos casos se mantiver restrições até ao Natal, diz ECDC
Biden aumenta vantagem no Wisconsin após recontagem exigida por Trump
- i-album
Cartoons
Cartoon Xira regressa com “grande exposição” do brasileiro Cau Gomez
O problema deve estar na comunicação de ciência. Se comunicarmos mais e melhor, todos estes problemas se resolvem. As pessoas passam a acreditar na ciência, seguem os conselhos dos cientistas, abandonam crenças e mezinhas. Fazer mais palestras, construir mais museus, abrir as portas dos laboratórios, ir à televisão, escrever nos jornais. Faz-se tudo isto, porque se acredita que resolve o problema. Mas raramente se faz o que é recomendado aos outros atores sociais (decisores políticos, empresas, cidadãos): sustentar a resolução de um problema em provas científicas. Que provas temos de que este tipo de ações resulta?
É preciso conhecimento científico para responder a esta pergunta: como é que se promove a confiança do público na ciência? Como é que se pode comunicar ciência de modo a que os cidadãos a entendam, e este entendimento tenha impactos no seu comportamento diário, nas suas escolhas políticas, na proteção contra os riscos e no desenvolvimento de vidas mais saudáveis e felizes? O projeto Concise: o papel da comunicação nas perceções e crenças dos cidadãos europeus sobre ciência quer contribuir para dar resposta a estas questões.
Ouvir os cidadãos
Em lugar de auscultar os cientistas ou os comunicadores sobre o que desejariam que o público soubesse sobre ciência, o Concise optou por ouvir os cidadãos sobre como eles gostariam que se fizesse a comunicação de temas científicos. Para isso, o projeto organizou consultas públicas a uma centena de cidadãos em cada país participante (Portugal, Espanha, Itália, Eslováquia e Polónia). Os cidadãos foram convidados a passar um dia a debater entre si como acedem a informação científica, em que canais a procuram, em que fontes confiam mais, o que os faz confiar na informação e, finalmente, como gostariam de ser informados. Em vez de debater a ciência “em geral”, escolhemos quatro tópicos atuais e com alguma dose de controvérsia: as alterações climáticas, os organismos geneticamente modificados (OGM), as vacinas e as medicinas alternativas ou complementares.
Em Portugal a consulta teve lugar há pouco mais de um ano, no Centro Cultural de Belém. Procurámos recrutar uma amostra diversificada, ainda que não representativa, da população portuguesa. Queríamos ouvir opiniões diversas, de pessoas de diferentes idades, regiões e com diferentes graus de ensino, de homens e mulheres, nacionais e estrangeiros, residentes em Portugal (a maioria de fora da Área Metropolitana de Lisboa). O grupo de participantes era bastante diverso, não obstante termos tido mais mulheres e mais pessoas com qualificações elevadas. Todas as discussões foram gravadas e transcritas, e depois sujeitas a uma análise de conteúdo qualitativa. São alguns resultados dessa análise da consulta em Portugal que aqui partilhamos.
Uma questão de confiança
Ao contrário de outros países, onde os movimentos anticiência têm uma expressão significativa, em Portugal as pessoas dizem ter uma elevada confiança na ciência, tendendo a associá-la a uma noção de “verdade”. Esta confiança não depende somente do seu entendimento sobre a validade do método científico, mas também da forma como acedem ou contactam com informação científica, ou seja, a confiança não se baseia apenas nos resultados científicos, ela depende muito do processo de comunicação dos mesmos: quem, que informação, em que formato, com que linguagem.
Os cidadãos reconhecem a complexidade do atual contexto da comunicação de informação científica, em que há múltiplos intervenientes e tem crescido a informação enviesada, falsa, sem credibilidade, opaca para o cidadão comum, resultado de eventuais campanhas de desinformação. É sem espanto que confirmamos uma maior confiança na informação científica proveniente de organismos oficiais do Estado e da comunidade científica (investigadores, unidades de investigação, ou universidades), vistos como motivados pelo interesse público e pela resolução de problemas sociais. Em sentido contrário, destaca-se a desconfiança no setor privado, designadamente na informação com origem em empresas ou resultante de investigação por elas financiadas (neste caso, empresas farmacêuticas ou de biotecnologia), motivadas por interesses comerciais ou pela maximização do lucro.
Já no caso das medicinas alternativas, as crenças individuais estão sobretudo assentes em experiências pessoais positivas com este tipo de terapias. Há, portanto, uma maior subjetividade na construção da confiança, pois esta deriva muito mais de dinâmicas interpessoais (o terapeuta que passa mais tempo com os pacientes, pergunta pela sua saúde em geral, adota uma abordagem mais holística) do que de uma avaliação da informação científica sobre o tema.
É notória, sobretudo entre os mais velhos, a perceção da deterioração da qualidade da comunicação científica, devido, sobretudo, à ausência de bons comunicadores, especialistas em determinados temas, capazes de agarrar a atenção do grande público. As pessoas recordam com nostalgia nomes como o do historiador José Hermano Saraiva, o engenheiro Sousa Veloso, o meteorologista Anthímio de Azevedo, a nível nacional, ou o comandante Jacques-Yves Cousteau ou o astrónomo Carl Sagan, a nível internacional, argumentando que atualmente quase não existem nomes equivalentes.
Sobre os jornalistas os comentários são menos abonatórios: o que as pessoas mais identificam são artigos demasiados curtos, notícias superficiais ou sensacionalistas, entrevistas agressivas, promoção de interesses políticos ou económicos. Ainda que reconhecendo as novas pressões sobre a comunicação social e a necessidade de os jornalistas seguirem uma agenda específica, os cidadãos consideram que tal não é compatível com a atenção que os temas científicos requerem.
Especificidades e ambivalências
Ainda que se possam identificar aspetos transversais, são inegáveis as especificidades de cada tópico. Enquanto os OGM estão praticamente ausentes do debate público, as alterações climáticas têm atualmente uma significativa exposição mediática, em publicações científicas, documentários, espaços noticiosos, ou na ação de ativistas globais como Greta Thunberg. Se as provas científicas sobre as alterações climáticas são comummente aceites pela população (são raros os negacionistas em Portugal), os transgénicos tendem a ser associados à discórdia entre ativistas ambientais e empresas de biotecnologia.
As pessoas prestam particular atenção à informação científica que é relevante para o seu dia-a-dia, para a sua profissão, para o bem-estar dos seus: os pais interessam-se mais por vacinas do que os adultos sem filhos, os agricultores sentem mais a falta de informação sobre os OGM do que os arquitetos.
A relação com a ciência também está cheia de ambivalências. Os que afirmam confiar inteiramente no médico de família para vacinar os seus filhos podem ser os mesmos que acusam os médicos de ter interesses corporativos na rejeição das medicinas alternativas. E, mesmo expressando essa profunda confiança nos profissionais de saúde, existe, todavia, uma vontade de que estes dediquem mais tempo a informar o paciente acerca dos benefícios e riscos na toma de uma vacina. O leitor ávido dos artigos sobre alterações climáticas na Nature pode ser um cliente habitual de reiki. O frequentador de osteopatas pode ser cético em relação às terapias homeopáticas, já que dentro do rótulo de medicinas alternativas se encontram práticas muito diferentes, até com diferentes graus de reconhecimento pelo Estado.
Na questão dos formatos da comunicação os mais jovens preferirão receber informação científica através de um vídeo de um influencer no YouTube e os mais velhos através de um livro de divulgação devidamente sustentado e ilustrado. A imagem da jovem Greta desperta em alguns a vontade de proteger o planeta para as novas gerações e noutros a irritação de se sentirem repreendidos por uma criança. Os ouvintes de rádio mencionam o programa 90 Segundos de Ciência, os leitores da imprensa internacional as reportagens do jornal The Guardian.
Queremos saber o que fazer
A consciência que os cidadãos têm de que a informação a que acedem, tanto a partir dos novos media como dos media tradicionais, apresenta muitas fragilidades faz com que desenvolvam ativamente múltiplas estratégias para a avaliar: por exemplo, a verificação da autoria, do financiamento, o aprofundamento dos assuntos ou a triangulação de fontes. No entanto, os cidadãos reconhecem a dificuldade em executar estes processos em relação a temas que não dominam, reivindicando uma maior certificação institucional da qualidade da informação científica. Simultaneamente, face à atual dispersão, pedem uma maior centralização, de modo a facilitar a pesquisa de informação científica credível.
O tema das alterações climáticas, em particular, tende a gerar uma sensação geral de impotência. Foi o tópico sobre o qual os cidadãos mais afirmaram sentir-se sujeitos a uma avalanche de informação, com uma cobertura mediática mais intensa e dramática (ou mesmo sensacionalista), focada mais nas catástrofes do que nos riscos graduais, menos visíveis. Em contraponto à informação veiculada nos media sobre os seus efeitos globais, os cidadãos querem saber que consequências terá o problema nas suas vidas e conselhos práticos para agir no sentido reduzir o seu impacto pessoal: que comportamentos são mais úteis para reduzir as emissões, que produtos comprar que tenham um custo ambiental menor, que contributos podem dar para proteger o planeta.
De igual modo, no que respeita ao tópico dos OGM, os cidadãos estão particularmente interessados na rotulagem dos produtos no supermercado. Querem saber exatamente o que estão a comprar e ter informação clara para poder escolher. Ainda que com respostas mais polarizadas, muitos cidadãos apontaram também a necessidade de maior regulação das práticas das medicinas alternativas (certificação de profissionais, um regime fiscal claro, demonstração científica da eficácia), mostrando que, apesar de a forma de relação com estas medicinas ser particularmente pessoal, como já referimos, o que as pessoas querem é a intervenção mais direta por parte do Estado, de forma a clarificar o próprio estatuto destas práticas na legislação portuguesa.
Em Portugal os cientistas têm uma imagem pública positiva e suscitam confiança por parte do público. Por isso os cidadãos envolvidos no nosso estudo reivindicam que as ações de comunicação de ciência tenham uma maior presença de cientistas: quer à distância, através de intervenções na televisão ou seminários; quer em eventos de proximidade, que envolvam as comunidades, incluindo as empresas e as escolas, mas sem deixar de lado os cidadãos. É claro que também pedem que a linguagem seja clara e acessível e que haja espaço para o debate e para a troca de ideias. Os cidadãos querem participar, querem aprender, mas também querem ser ouvidos.
Uma palavra final para o tema do momento. Esta consulta pública foi feita meses antes do início da pandemia covid-19, como se pode constatar na imagem dos participantes que ilustra este artigo. Não podemos especular que respostas teríamos hoje às perguntas que colocámos na altura, tendo em conta a extraordinária crise de saúde pública que estamos a atravessar. Mas cremos que muito do que aprendemos com os participantes se mantém válido e permite retirar ilações importantes sobre como comunicar a informação científica, bem como as recomendações para impedir a propagação do vírus. Campanhas multimeios para chegar a diferentes públicos, a presença de cientistas para conferir autoridade científica às notícias, recomendações exatas e práticas sobre o que cada cidadão pode fazer para prevenir o contágio ou para evitar contagiar os outros, informações claras e rigorosas, por parte das autoridades públicas, sobre a base científica que sustenta as medidas tomadas são tudo formas de melhorar a comunicação de ciência e atingir os efeitos desejados.
O projeto Concise é financiado pela Comissão Europeia ao abrigo do programa de investigação e inovação Horizonte 2020 (GA nº. 824537). É coordenado por uma equipa da Universidade de Valência (Espanha) e tem a participação do Instituto de Ciências Sociais da Universidade de Lisboa e outros parceiros de cinco países
Socióloga; cientista político; socióloga